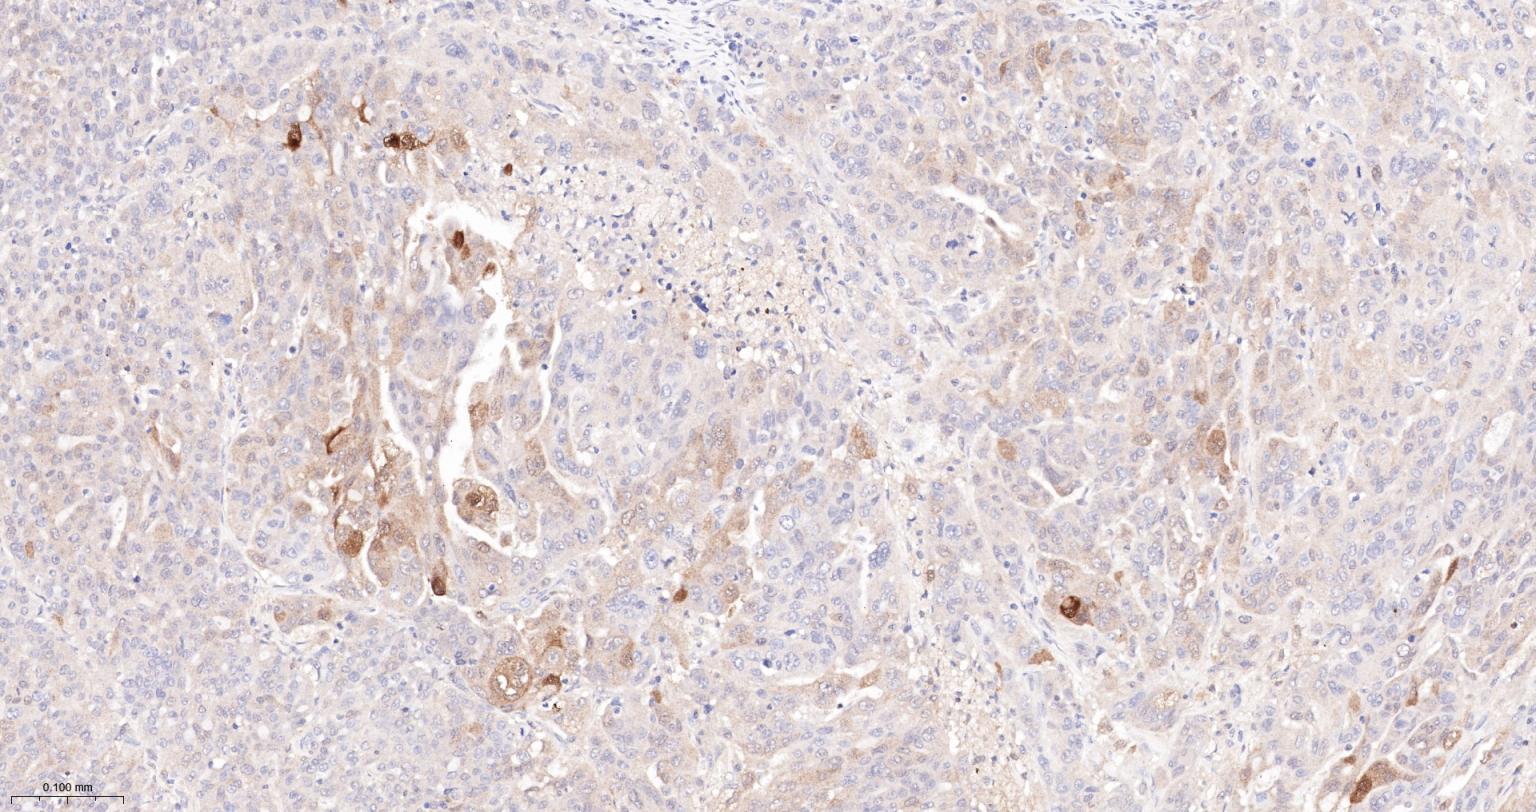
半乳糖凝集素3重组兔单抗

半乳糖凝集素3重组兔单抗

概述
This gene encodes a member of the galectin family of carbohydrate binding proteins. Members of this protein family have an affinity for beta-galactosides. The encoded protein is characterized by an N-terminal proline-rich tandem repeat domain and a single C-terminal carbohydrate recognition domain. This protein can self-associate through the N-terminal domain allowing it to bind to multivalent saccharide ligands. This protein localizes to the extracellular matrix, the cytoplasm and the nucleus. This protein plays a role in numerous cellular functions including apoptosis, innate immunity, cell adhesion and T-cell regulation. The protein exhibits antimicrobial activity against bacteria and fungi. Alternate splicing results in multiple transcript variants.[provided by RefSeq, Oct 2014]

产品应用
| 应用 | 已检合格种属 | 预测种属 | 推荐稀释比例 |
|---|---|---|---|
| WB | Human | 1:1000-5000 | |
| IHC-P | Human | 1:200-800 | |
| IHC-F | Human | 1:200-800 | |
| IF | Human | 1:200-800 |
交叉反应
交叉反应: Human
相关产品
暂无相关产品
靶标
标记抗体
暂无标记数据
同靶标产品
暂无同靶标产品
相关文献
暂无相关文献
常见问题
暂无常见问题